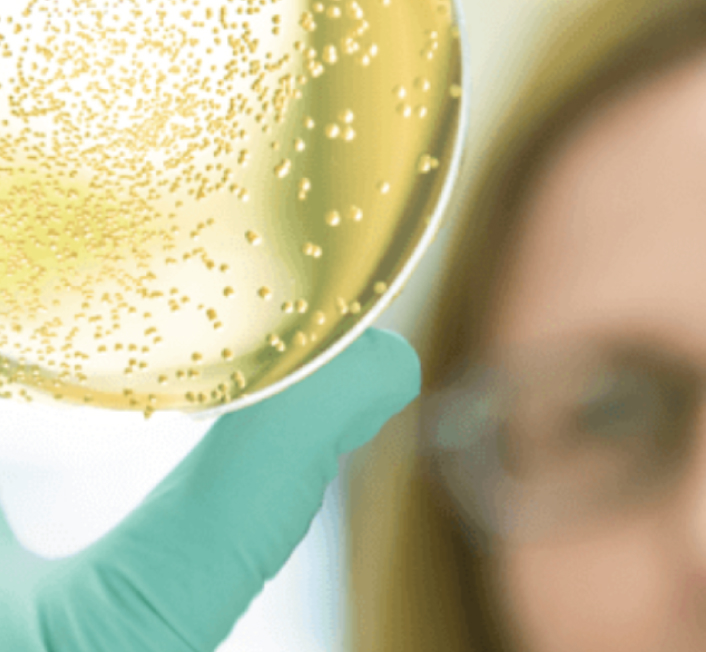

Hello. I'm Erik Sonlin, a Philadelphia-based Creative Director, UI/UX Designer, and guitar strumming enthusiast.
I have over 20 years of creative problem solving expertise in Marketing and Product Design. My varied industry experience includes: Life Sciences, Health Systems, Technology, QSR, Consumer Products, Financial, and Music and Entertainment.

corporate website

QSR loyalty brand

automotive media center

employee portal

material science webiste

brand concept mood boards

streaming service website

AI-powered member experience

Mechanism of Disease Animation

consumer pharma promotions
